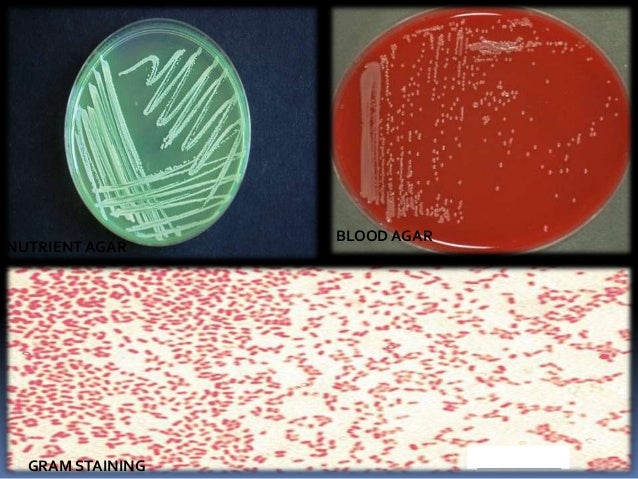

- Alternatives to proteus VSM for Linux, Windows, Mac, Web, Self-Hosted and more. Filter by license to discover only free or Open Source alternatives. This list contains a total of 21 apps similar to proteus VSM. List updated: 9/22/2019 2:38:00 PM.
- Proteus Design Suite 8.10 SP3 Crack Mac Professional Free Download Latest 2020 Proteus 8.10 SP3 Crack for Mac Overview: Proteus 8.10 SP3 Crack for Mac is a tool for designing and configuring electronic devices based on different micro-controllers from different families.This software allows to introduce the circuit in a graphic editor, to model its operation and to develop printed circuits.
- Proteus For Mac Download
- Proteus For Mac Free Download
- Download Proteus 7.8 Professional
- Download Proteus 8.2 Full Crack
Proteus 8.8SP1 Crack + License Key Free Download 2020 Proteus Crack used in hands of Electrical & Mechanical Engineers for the Drawing of Professional PCB Circuit Drawings in 2D/3D Format, Import Drawings, Enhance Project Look, Share Files, CAD Files Format Conversion, Manage Mosaic, Side Bar Editing also.
Proteus 8.8SP1 Crack + License Key Free Download [2020]
Proteus Crack used in hands of Electrical & Mechanical Engineers for the Drawing of Professional PCB Circuit Drawings in 2D/3D Format, Import Drawings, Enhance Project Look, Share Files, CAD Files Format Conversion, Manage Mosaic, Side Bar Editing also. This program is designed by the Developers team of “Labcenter Electronics Ltd” taking in front of all the Major Drawing Features/Tools.

Proteus For Mac Download

With the help of Proteus Crack, Draw all the types of Circuit Sketches including the Operating Systems Processors, Home Electricity Circuits, Machinery Structures, Headphone Circuits, Keyboards, Mobile Phone Circuits, Hard-Drive, Manage Positive & Negative Points, Manage Electricity Passing Way. An extremely outstanding Proteus Full Keygen which used in the hands of Engineers, Mechanical Engineers, PCB Circuit Designers in the format of 2D & also in the 3D Format with the Modern Interface. It has the user-friendly interface & also updated version is totally cleaned from all the types of Minor Bugs & Issues.
Proteus 8 Modern Features
- Fully prepared program with all the Tools & Features, Pens, Pencils & Draw Lines.
- Basically use of this tool in the Computers & Electrical Engineers for Managing the Circuits.
- It allows managing the Circuits Positive & Negative Points of Electricity Crossing.
- Through this tool, Operator can Draw PC Circuit, Processor, Hard-Drive Circuits.
- It has the User-Friendly Professional Interface with the Modestive Layout.
Related 2D/3D Drawings Creation Tool’s
Cimatron E13 Crack
SpaceClaim Crack
SolidCam Crack
System Required
- Microsoft Windows.
- 1.4 Micro Processor.
- 1GB Os RAM.
- Free Hard-Drive Space.
Working Activation Codes
YH2J3K4N6P7Q9SATBVDWEXGZH2
DXFYGZJ3K4M6P7Q8SATBUDWEXF
UCVDWFYGZH3K4M5P7Q8RATBUCW
9SATCVDWEYGZH2K4M5N7Q8R9TB
P7Q9SATBVDWEXGZH2J4M5N6Q8R
If keys are not working, follow the installation process.
How To Install Free?
- A CAD-Based program which used for the Designing of Professional PCB Circuits.
- Download the file of Proteus Cracked in the HDD.
- Un-Extract setup with the help of “WinRAR”.
- Install the full setup in the OS C-Drive.
- Tap On The Installed Program & Use All Those Modern Objects Which Is Used For The 2D & 3D Format PCB Circuit Drawings.
https://systechnosoft.com/r5rabfa57a294374e1689deb2ed1d2a02195f9db63e03?q=Proteus 8.8 SP1 Crack Plus Full 2020 Keygen [Latest] Download
Logitech G502 proteus spectrum software and driver: Computer gamers have an urge to have gaming accessories which include gaming headset, gaming mouse, etc.
Among all other gaming mice, Logitech G502 Proteus Spectrum gaming mouse is the best choice for all the pro gamers.
Logitech G502 proteus spectrum
Logitech G502 proteus spectrumIf you are looking where you can download Logitech G502 Proteus Spectrum gaming mouse software and driver, then you are in the right place, here is the required software (Logitech gaming software + Logitech G HUB) which is available at the end of this article with a direct download link. We will also discuss the download process in your device. For your convenience, we have listed the current version of the software available for Logitech G502 Proteus Spectrum gaming mouse.
In this article, we will first have an idea about the features of Logitech G502 Proteus Spectrum gaming mouse which makes it a unique one.
Logitech G502 Proteus Spectrum gaming mouse features
Logitech G502 Proteus Spectrum has been awarded as 'the gamer's choice' because of its extra-ordinary features along with amazing gaming experience. Thus, before downloading the required Logitech g502 software, we have listed the features:
- Logitech G502 Proteus Spectrum gaming mouse has been highly equipped with a PMW3366 optical sensor which exhibits zero acceleration through 200- 12,000 DPI range. Thus, the sensor helps the mouse with tracking accuracy and respond quickly irrespective of the settings done with the mouse.
- This gaming mouse has the option to add sensitivity with the transition from a low DPI range of 200 to high sensitivity DPI range of 12,000. This high sensitivity DPI range can be programmed using Logitech Gaming software. You can set up to 5 DPI settings to Logitech G502 Proteus Spectrum gaming mouse. Thus the indication of light makes you aware of the DPI settings.
- Logitech G502 Proteus Spectrum gaming mouse has a scrolling wheel that works on dual-mode; On unlock mode, it is very easier to scroll up-down and with a single click on the wheel, it will be in lock mode. These two modes provide confidence and control on the mouse for use.
- It has been equipped with eleven programmable buttons which help to save the commands required to access quickly during a game.
- Logitech G502 Proteus Spectrum gaming mouse has been engineered with primary buttons designed mechanically up to 20 million clicks. It also has rubber on both sides for better gripping.
- It is a cost-effective mouse available in the market.
About Logitech G502 software
Now, you need to have the details of the driver versions available on the internet for Logitech G502 Proteus Spectrum gaming mouse. The Logitech G hub software is compatible with Logitech G502 Proteus spectrum. Before downloading this software, you need to check the driver compatibility with your device or OS (Windows or MAC). So, check the driver details as below:
G502 Proteus Spectrum driver for Windows OS
Logitech Gaming Software
Driver version: 9.02.65
Released: 08th October 2018.

Compatible: Windows 10 (32/64 bit).
Windows 8 (32/64 bit).
Windows 7 (32/64 bit). Download java for mac firefox.
File: 111.7 MB (32 bit), 123 MB (64 bit).
Logitech G HUB
Driver version: 2020.2.35921
Released: 02nd April 2020.

Compatible: Windows 10 (32/64 bit).
Windows 8 (32/64 bit).
Windows 7 (32/64 bit).
File: 35.6 MB.
G502 Proteus Spectrum driver for MAC OS
Logitech Gaming Software
Driver version: 9.02.22
Released: 18th January 2020.
Compatible: MAC OS X 10.15
MAC OS X 10.14
MAC OS X 10.13
MAC OS X 10.12
File: 213.1 MB.
Logitech G HUB
Driver version: 2020.2.35921
Released: 02nd April 2020.
Compatible: MAC OS X 10.15
MAC OS X 10.14
MAC OS X 10.13
MAC OS X 10.12
File: 29.7 MB.
Please note that the current driver download link is given at the end of this article.
How to install Logitech G502 Proteus Spectrum gaming software in Windows 10 and Mac?
For better working of Logitech G502 HERO gaming mouse, you need to install Logitech G HUB & Logitech gaming software. For both the software, we need to repeat the same process given below:
- First, you need to browse https://support.logi.com/.
- Then, go to the search panel and type your device name 'G502 proteus spectrum'. Thus, the search results end to the downloads section.
- Under 'Downloads', you will find the required software such as Logitech G HUB & Logitech gaming software.
- Click on the download button below the specified software.
- After downloading, you need to right-click on the file to install it in Windows or MAC.
- The welcome window followed by the option of choosing the preferred language.
- You must tick on 'Accept' on terms & conditions. Click on Finish after installation.
- Finally, restart your device for the better working of the software.
How to Update Logitech G502 Proteus Spectrum gaming software?
Every update in the Logitech gaming software comes with some additional features. To update Logitech G502 Proteus Spectrum gaming software, you need to execute the steps properly in the given sequence:
- First, you need to browse https://support.logi.com/downloads
- Then, search your device name 'G502 Proteus Spectrum' in the search panel. The installed software will be enlisted under 'Downloads' with its current version.
- Install the current driver version replacing with the previous version of the software.
- After downloading, double click on the file and start the process of installation.
- Once the software gets installed, restart your PC or laptop for better performance.
Logitech G502 Proteus Spectrum driver not working in Windows 10
Every user of G502 Proteus Spectrum faces an issue with the updated version of Windows 10. After expert analysis, they have provided a solution to fix this issue that is persistent with approximately thousands of users. To fix this issue, follow the below steps:
- Press & hold on the Windows button and 'X' together.
- Under 'Device Manager', you have to check for 'Logitech G502'. If there is a yellow mark beside G502, then you have to uninstall the installed software.
- Then, reinstall the drivers and restart your device.
Download Logitech G502 Proteus spectrum driver
- Logitech G hub software Logitech G502 Proteus Spectrum for Windows 10 32/64 bit
Proteus For Mac Free Download
Download now- Logitech G hub software G502 Proteus Spectrum for macOS
- Logitech G502 Proteus Spectrum setup guide
Download Proteus 7.8 Professional
Download nowDownload Proteus 8.2 Full Crack
